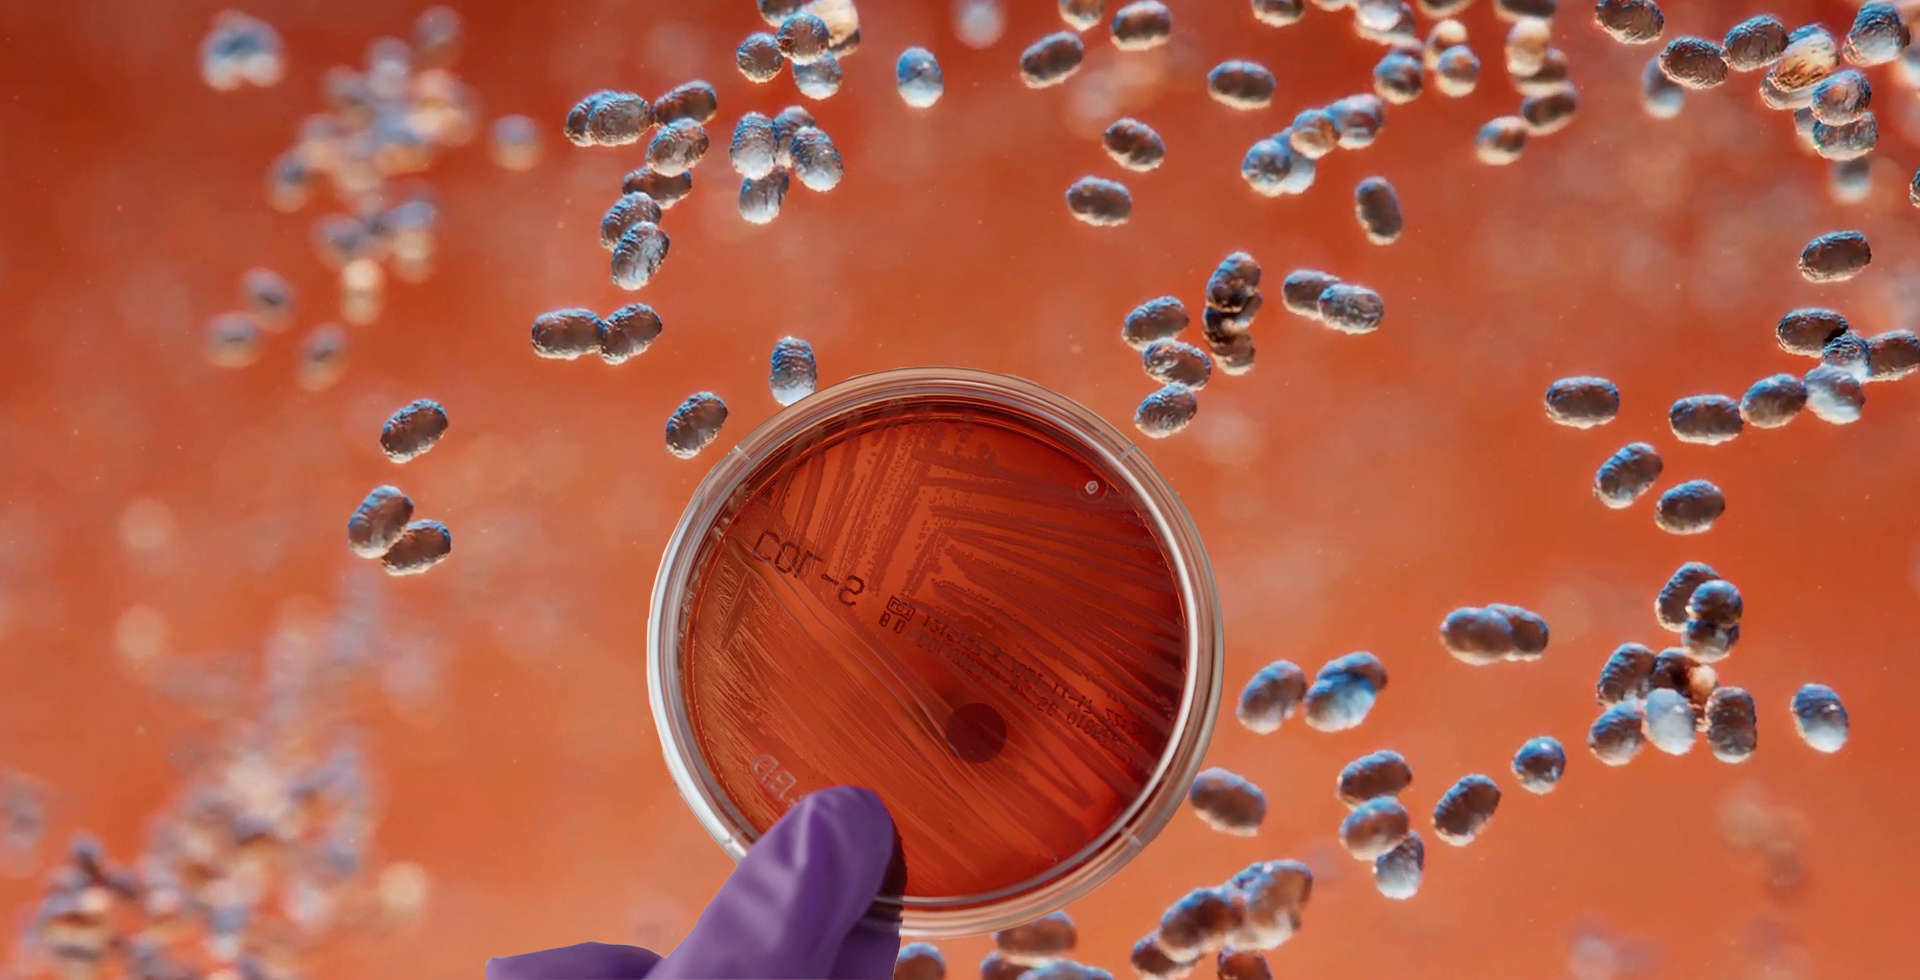
Maldi-tof Sistema

MALDI-TOF Biotyper
Sistema de espectrometría de masas para microbiología que se utiliza para una identificación microbiana rápida.
- Identifica bacterias gram+ y gram-, levaduras y hongos mediante su huella dactilar proteómica.
- El sistema es compatible con la racionalización de antibióticos.
- Cuenta con bases de datos completas y abiertas para ahorrar tiempo y optimizar flujos de trabajo.
- Ofrece rapidez en la obtención de resultados para optimizar el pronóstico de enfermedades.
- Cumplimiento con CFR 21 parte 11.

MALDI Biotyper
Espectrómetro de masas MALDI-TOF para microbiología.
Ver más...
- Utiliza ionización láser asistida por matriz y analizador tiempo de vuelo (MALDI-TOF).
- Permite identificar en cuestión de minutos colonias bacterianas aisladas en medios de cultivo sólidos y líquidos.
- Los diferentes tipos de medio de cultivo y las condiciones ambientales no afectan los resultados.
- La identificación de microorganismos se realiza mediante la comparación de espectros acelerando los flujos de trabajo.
- El software automatiza el proceso de adquisición del espectro de masas y la comparación con la biblioteca de referencia.
- Se puede realizar la identificación total de una placa de 96 pocillos en 20 minutos.
- Cuenta con un lector de código de barras para una rápida consulta y monitoreo de muestras.
Estamos listos para ayudarte
Contacta a uno de nuestros especialistas para recibir una asesoría personalizada sobre estos equipos o cotiza
INOLAB ESPECIALISTAS DE SERVICIO S.A. DE C.V.
Aniceto Ortega No.1341, Colonia del Valle, C.P. 03100, Ciudad de México.Ciudad de México
55 5524 2429
Guadalajara
33 3330 2848
Relacionados
Preguntas Frecuentes
- ¿Qué es MALDI-TOF y cómo funciona?
- MALDI-TOF (Matrix-Assisted Laser Desorption/Ionization - Time of Flight) ioniza macromoléculas (proteínas, péptidos, polímeros) con pulsos de láser sobre una matriz cristalizada. Los iones se aceleran y separan por su tiempo de vuelo, generando un espectro de masas preciso en microsegundos.
- ¿Cuáles son las aplicaciones de MALDI-TOF en microbiología?
- MALDI-TOF es la tecnología de referencia para identificación rápida de microorganismos en laboratorios clínicos y de control de calidad. En minutos identifica bacterias, levaduras y hongos a nivel de especie a partir de una colonia, con alta confiabilidad y bajo costo por análisis.
- ¿Qué otras aplicaciones tiene MALDI-TOF fuera de microbiología?
- Se usa en proteómica (fingerprinting de proteínas, identificación de péptidos digeridos), caracterización de polímeros sintéticos, análisis de oligonucleótidos, glicómica y control de calidad de biofármacos para verificar masa molecular e integridad del producto.
- ¿Cuánto tiempo tarda una identificación por MALDI-TOF?
- La preparación de muestra toma menos de 5 minutos (aplicación directa de colonia + matriz). La adquisición del espectro es cuestión de segundos. El resultado final, incluyendo comparación con la base de datos, está disponible en menos de 10 minutos.
- ¿Requiere MALDI-TOF mantenimiento frecuente?
- Es un equipo de bajo mantenimiento: limpieza periódica del target de muestra, calibración con estándares de referencia proteicos y verificación del láser. Inolab ofrece contratos de servicio y actualización de bases de datos microbiológicas para mantener la plataforma actualizada.